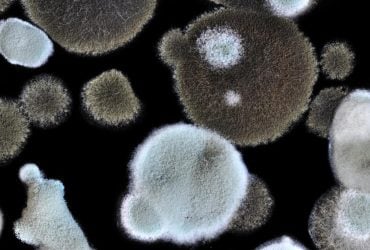

Цей фрукт ніколи не ріс у дикій природі, а з’явився шляхом гібридизації.

Більшість людей вважають, що лимон, як і інші фрукти, подарувала нам природа / фото ua.depositphotos.com
Більшість людей сприймають лимон як один із багатьох фруктів, які подарувала нам природа. Однак насправді це не так. Виявляється, лимон вивели люди шляхом гібридизації та ретельного культивування. Про це пише американський еволюційний біолог із Ратгерського університету Скотт Треверс у своїй колонці для Forbes.
За його словами, задовго до того, як генетика чи селекція рослин стали розвиненими галузями, у І тисячолітті до н. е., перші землероби в Південно-Східній Азії вже ухвалювали рішення, які перетворили дикі види цитрусових на гострий, ароматний фрукт, який ми знаємо сьогодні.
Як ідеться в дослідженні, опублікованому у Bulletin of the Torrey Botanical Club, лимон (Citrus limon) є “дитиною” двох давніших фруктів – гіркого апельсина (Citrus × aurantium) та цитрона (Citrus medica). Однак жоден із “батьків” не схожий на цей яскравий, інтенсивно кислий фрукт. Тисячі років тому люди відбирали дуже специфічні ознаки, що не траплялися в природі: підвищену кислотність, товстішу шкірку та міцну цедру, яка добре переносить транспортування.
Згідно з цим дослідженням, лимон, імовірно, був створений десь у північній Індії або північній М’янмі. Протягом наступних століть його вдосконалювали селекційним шляхом. Це означає, що так само, як домашні собаки з’явилися з вовків шляхом цілеспрямованого розведення, лимони з’явилися внаслідок навмисного схрещування та відбору прадавніх цитрусових. Іншими словами, лимони створила не природа – їх створили люди, пояснив біолог.
Читайте також:
Один вид грибка з Чорнобилю захищає від радіації краще, ніж свинцеві стіни, – дослідження

Археологи знайшли таємничу могилу із загадковими ритуальними предметами

Як давньоримські споруди збереглися до сьогодні: вчені назвали секрет будівельників
“Причина появи лимона проста: люди хотіли фрукт, який би робив те, чого не міг жоден натуральний фрукт у той час, – зберігав їжу, маскував запах псування, дезінфікував поверхні та додавав стравам насиченої кислоти. Після того, як лимон був створений, він швидко поширився торговими шляхами як біохімічний багатоцільовий інструмент, який можна було використовувати як ліки, приправу та консервант для транспортування на великі відстані”, – йдеться у матеріалі.
Усі цитрусові дуже легко піддаються гібридизації
Десятиліттями точилися суперечки про точне ботанічне походження лимона. На щастя, пише Треверс, дослідження 2016 року, опубліковане в Annals of Botany, використало масштабний генетичний аналіз – комбінацію хлоропластної ДНК, мітохондріальних маркерів та понад 120 ядерних маркерів – для 133 різних цитрусових і їхніх диких родичів. Дослідники змогли відтворити історію появи сучасних лимонів і лаймів.
Результати показали, що лимони виникли внаслідок численних міжвидових гібридизацій. Простіше кажучи, їх ДНК дуже різноманітна: у ній є сліди різних цитрусових, а кінцевим спільним предком є цитрон, стверджує науковець.
Утім, лимони – не єдині виведені фрукти. За словами Треверса, всі цитрусові незвично легко піддаються гібридизації, і люди сповна цим скористалися. Інше дослідження 2016 року простежило “батьківську” лінію лимонів серед сотень цитрусових сортів і підтвердило, наскільки заплутаними є цитрусові “родинні дерева”:
- апельсини (солодкі й гіркі) – це гібриди помело та мандарина;
- лайми походять від цитрона, змішаного з іншою давньою лінією цитрусових;
- грейпфрути, ймовірно, з’явилися внаслідок схрещення між солодким апельсином і помело;
- танжори, танжело та клементини також є штучно створеними цитрусовими.
Це означає, що відділ цитрусових у супермаркеті – це, по суті, виставка біорізноманіття, створеного людиною, зазначив Треверс. На відміну від багатьох “дикорослих” фруктів – маленьких, гірких і з великою кількістю насіння – цитрусові були ретельно виведені для смаку, зручності збору, зберігання, а також кулінарних і косметичних властивостей.
Чому важливо знати історію цього фрукта
За словами ученого, розуміння походження цитрусових показує, що вже давні люди задовго до існування сучасної генетики чи лабораторної науки глибоко впливали на екосистеми та біорізноманіття. У цьому сенсі культивація та одомашнення може вважатися давнім людським мистецтвом, а не “сучасними” винаходами.
Коли ми називаємо фрукти “органічними” чи “натуральними”, ми часто просто маємо на увазі, що вони ростуть на деревах, пише Треверс. Але багато з того, що ми вважаємо натуральним (і лимони в тому числі), насправді має форму, глибоко сформовану людським втручанням. Це допомагає переосмислити наші уявлення про те, що є “природною” чи “справжньою” їжею.
“Історія лимона – це зрештою історія людської винахідливості. Щоразу, коли ви віджимаєте його в страву чи у склянку води, ви користуєтесь інструментом, який формували незліченні покоління людей”, – підсумував біолог.
Раніше УНІАН писав про єдиний на планеті синій фрукт, який насправді не синій. Йдеться про блакитний квандонг, який росте у тропічних лісах Австралії та Південно-Східної Азії. Його плоди настільки неймовірно кобальтові, що більшість людей припускає, що цей колір підсилено цифровим способом або за допомогою штучних барвників.
З’ясувалося, що цей синій колір є фізичною властивістю шкірки плоду, а не хімічною. Його секрет – у багатошаровій будові клітинних стінок, розташованих у точних наноструктурованих шарах, які відбивають і підсилюють певні довжини хвиль світла.





